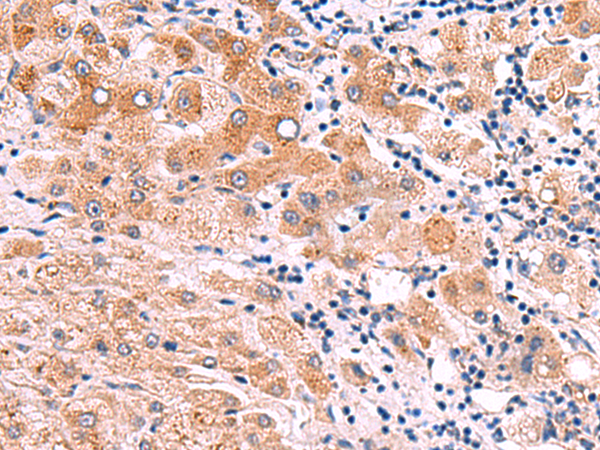

技術規格
Background:
This gene encodes an alpha integrin. Integrins are heterodimeric integral membrane proteins composed of an alpha chain and a beta chain. This protein contains an I domain, is expressed in muscle tissue, dimerizes with beta 1 integrin in vitro, and appears to bind collagen in this form. Therefore, the protein may be involved in attaching muscle tissue to the extracellular matrix. Alternative transcriptional splice variants have been found for this gene, but their biological validity is not determined.
Applications:
ELISA, IHC
Name of antibody:
ITGA11
Immunogen:
Synthetic peptide of human ITGA11
Full name:
integrin subunit alpha 11
Synonyms:
HsT18964
SwissProt:
Q9UKX5
ELISA Recommended dilution:
5000-10000
IHC positive control:
Human tonsil and Human liver cancer
IHC Recommend dilution:
50-300

購物車
幫助
021-54845833/15800441009
